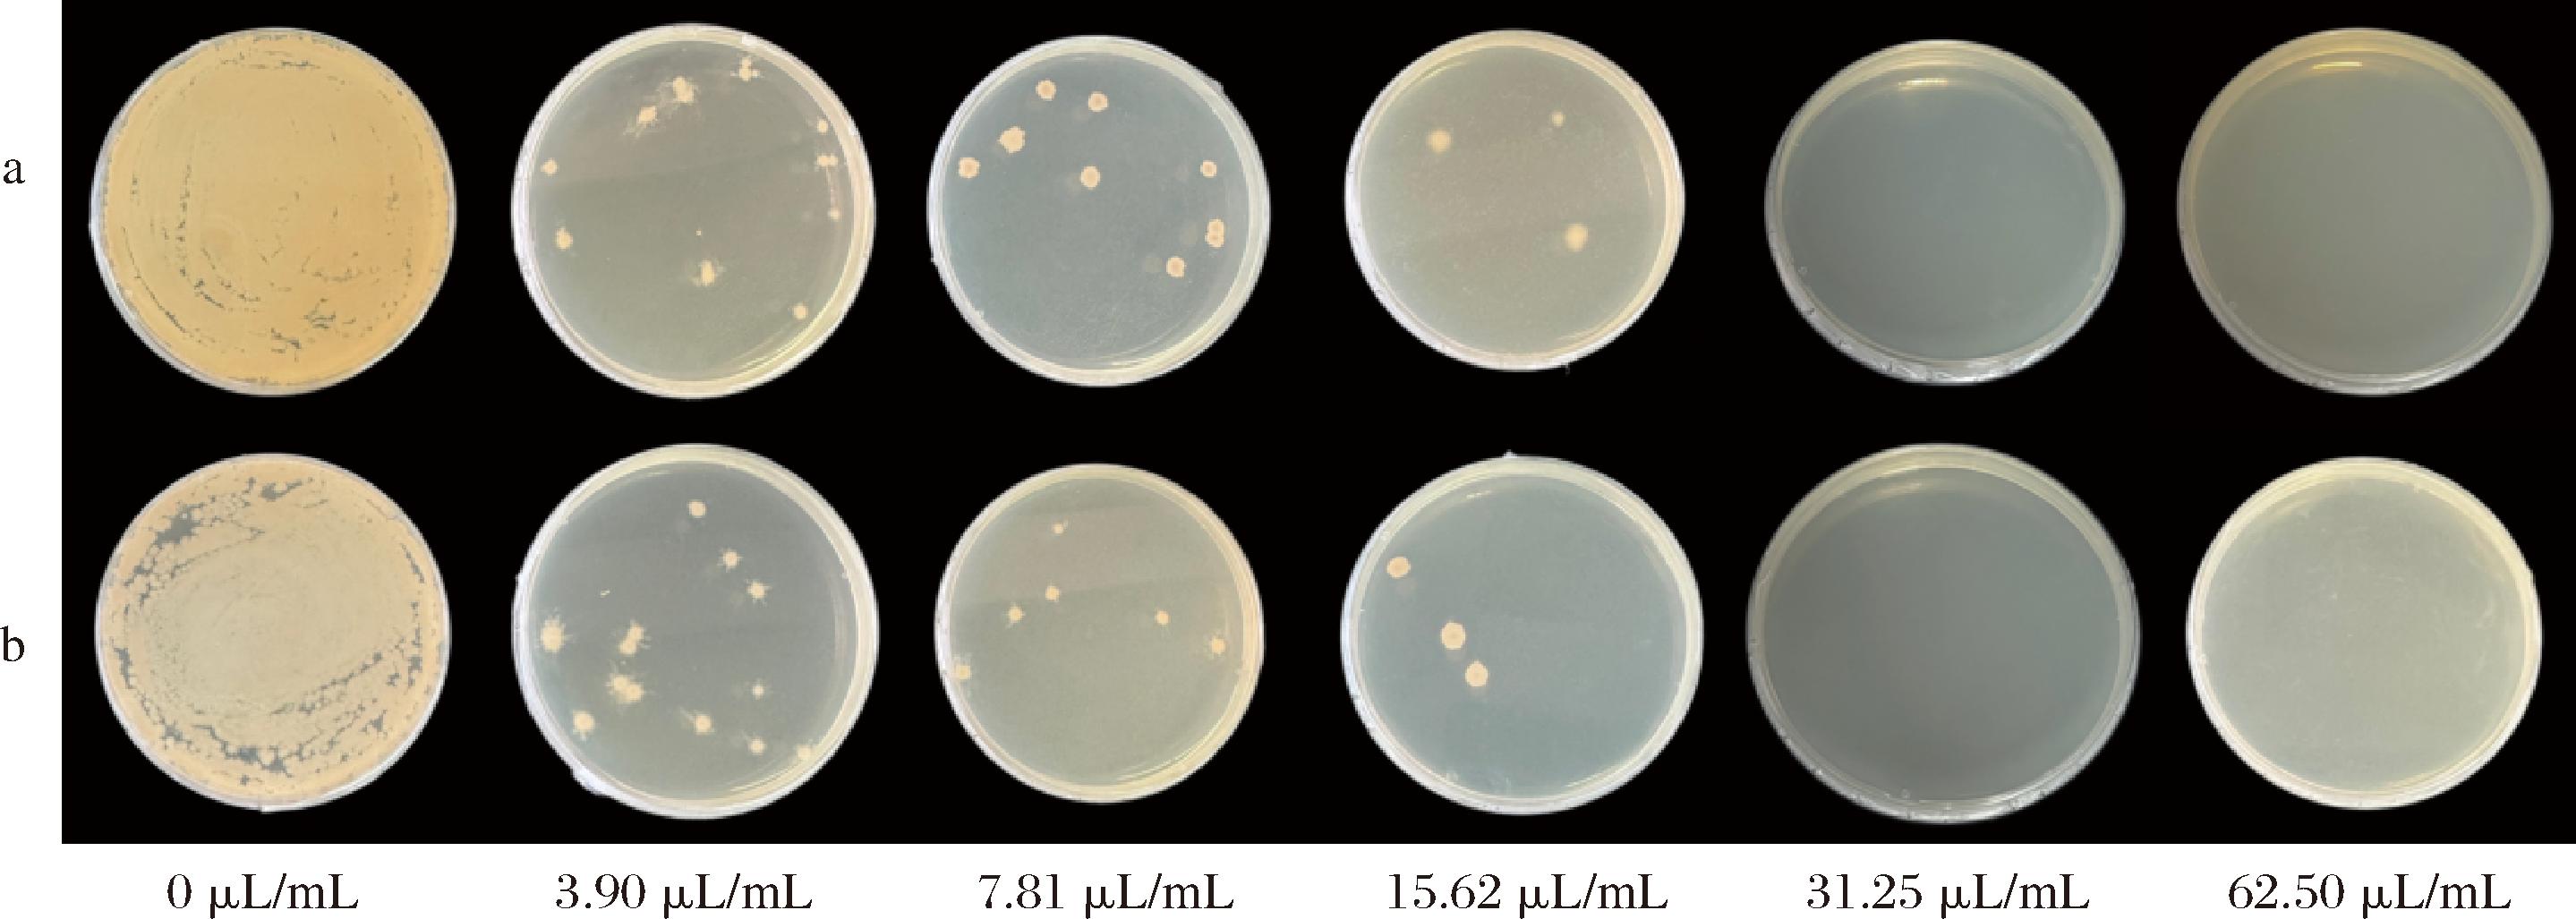

百里香精油(thyme essential oil,TEO)是一种具有安全环保、广谱抑菌等优势的天然抗菌剂[1]。通过纳米乳化技术负载百里香精油可以改善其易挥发、刺激性气味大、水溶性差等问题,进而提升其在食品体系中应用的抗菌、抗氧化等效果[2]。研究表明,在负载精油的纳米乳液制备过程中,不溶性植物油的添加可以减小乳液的平均粒径[3]。这主要是因为植物油的添加不仅可以抑制乳液的奥氏熟化作用,还可以减小油相和水相之间的密度差,从而通过克服重力分离使乳液稳定性得到提高[4]。ZHAO等[5]在大蒜精油纳米乳液中添加植物油发现植物油的添加可以减小乳液的粒径并提高其物理稳定性及包封效率。JULIAN等[6]证实了在油相中添加10%以上的玉米油,可以有效抑制橙油乳液贮藏过程中乳滴粒径的增大。然而,植物油的加入使精油纳米乳液油相中的有效抗菌物质浓度降低,导致其抗菌活性下降[3]。因此,可以通过添加百里香酚等精油主要的抗菌活性成分来改善这一问题。
百里香精油纳米乳液在实际食品体系中应用时,易受到环境因素如pH、Na+浓度等的影响,使其稳定性下降。研究表明,纳米乳液的理化性质与稳定油水界面的表面活性物质的性能显著相关,可通过优化表面活性物质的制备条件、质量浓度等来调控[7-9]。此外,乳液中油相的种类及占比也会影响表面活性物质在油水界面的性能[10]。BAI等[11]制备了具有不同油相的Pickering乳液,研究发现,用柠檬油制备的乳液的平均液滴直径远大于使用玉米油、中链甘油三酸酯或鱼油制备的乳液。ONAIZI[12]采用十二烷基苯磺酸钠配制并稳定了原油水包油 (O/W) 纳米乳液,发现分散相体积分数的降低使得相对更多的表面活性物质发挥其降低体系界面张力和乳液粒径的作用。因此,当油相中存在精油、不溶性植物油、抗菌物质等多种组分时必然会影响表面活性物质的性能和乳液的稳定性。综上所述,通过系统研究乳液中表面活性物质制备工艺及混合油相中成分和比例,有望制备出一种具有良好稳定性和抑菌性能的混合油相纳米乳液。
因此,本研究以乳清分离蛋白(whey protein isolate, WPI)与低酯果胶(low methoxyl pectin, LMP)复合颗粒(WPI-LMP)作为乳化剂,以百里香精油/大豆油/百里香酚为混合油相,探究水相pH、WPI与LMP质量比、WPI-LMP质量浓度、混合油相体积分数和百里香酚添加量对混合油相的纳米乳液平均粒径和包埋率影响的规律,并评价负载百里香精油/大豆油/百里香酚混合油相的纳米乳液(mixed oil phase nanoemulsion, MONE)的稳定性及抑菌性。本研究可为负载MONE的制备提供技术基础。
1 材料与方法
1.1 材料与试剂
WPI,恒天然合作社集团有限公司;LMP,安德利果胶股份有限公司;百里香精油,吉安市中香天然植物有限公司;百里香酚,天津市科密欧化学试剂有限公司;大豆油,益海嘉里金龙鱼食品集团股份有限公司;盐酸、NaOH、正己烷、NaCl、琼脂粉,天津市天力化学试剂有限公司;胰蛋白胨、酵母浸粉,北京奥博星生物技术有限责任公司。
1.2 仪器与设备
PHS-3C pH计,上海仪电科学仪器股份有限公司;FJS-6数显恒温水浴锅,上海维诚仪器有限公司;F18高速剪切分散乳化机,上海弗鲁克科技发展有限公司;SCIENTZ-150高压均质机,宁波新芝生物科技股份有限公司;BT-9300ST激光粒度分析仪,丹东百特仪器有限公司;TU-1900双光束紫外可见分光光度计,北京普析通用仪器有限责任公司;MS60光学显微镜,广州市明美科技有限公司。
1.3 实验方法
1.3.1 MONE的制备
参考刘珍珍等[9]的研究方法,略有修改。称取一定质量的WPI粉末与LMP粉末溶于去离子水中搅拌12 h,待完全水化后,利用0.1 mol/L的HCl溶液或NaOH溶液调节为不同pH值,磁力搅拌10 min使WPI和LMP之间进行相互作用。随后以80 ℃水浴加热15 min,立即冰水浴冷却至室温,即得到WPI-LMP复合颗粒。
在百里香精油与大豆油的混合油相(体积比为3∶1)中加入一定量的百里香酚,与一定体积的WPI-LMP复合颗粒溶液混合至100 mL,将混合物进一步搅拌10 min,然后利用高速剪切机(剪切速率13 000 r/min,时间1 min)与高压均质机(50 MPa,循环4次)进行MONE的制备。
1.3.2 MONE制备条件研究
在WPI与LMP质量比1∶2、复合颗粒质量浓度25 g/L、水相pH 5.0、混合油相体积25 mL、百里香酚添加量为混合油相体积的5%条件下,分别考察不同水相pH值(4.0、4.5、5.0、5.5和6.0)、WPI与LMP质量比(2∶1、1∶1、1∶2、1∶3、1∶4)、复合颗粒质量浓度(15、20、25、30、35 g/L)、混合油相体积(10、15、20、25、30 mL)、百里香酚添加量(混合油相体积的1%、2%、3%、4%、5%)条件下,MONE的平均粒径和包埋率的变化。
1.3.3 乳液粒径测定
将MONE用去离子水稀释后采用激光粒度分析仪测定乳液的平均粒径。仪器参数:折射率1.450,测试温度25 ℃,平衡时间30 s,每个样品测试3次。
1.3.4 包埋率的测定
在1 mL样品中加入5 mL正己烷,漩涡振荡混合均匀,5 000 r/min的速度离心10 min,随后取上清液并稀释,于最大吸收波长274 nm处测定稀释后样品的吸光度,通过预先建立的标准曲线(R2>0.999)与公式(1)计算乳液包埋率(encapsulation efficiency, EE)。混合油相的包埋率参照刘珍珍等[9]的方法。
(1)
式中:EE,混合油相包埋率,%;C0,加入的精油总量,mL;C,游离的精油总量,mL。
1.3.5 MONE稳定性测定
1.3.5.1 pH稳定性测定
参考GAO等[13]的方法并稍做修改。利用0.1 mol/L HCl溶液或0.1 mol/L NaOH溶液调节乳液的pH值分别为3、4、5、6和7,调节后的乳液搅拌3 h后利用去离子水进行稀释,测定不同pH值下乳液液滴的粒径。
1.3.5.2 Na+稳定性测定
参考YANG等[14]的方法并稍作修改。在乳液中加入一定量的NaCl溶液,使乳液中Na+浓度分别为0、50、100、200、400 mmol/L,调节后的乳液搅拌3 h后利用去离子水进行稀释,测定不同盐离子浓度下乳液液滴的粒径。
1.3.5.3 贮藏稳定性测定
按照1.3.1节选定的最优工艺条件制备MONE,将其分装后保持直立状态放置于4 ℃冰箱中,在不同的贮存时间(0、5、10、15、20、25和30 d)对乳液的外观、粒径、包埋效率以及微观结构进行测定。通过这些指标的变化,评估MONE在贮存过程中的稳定性。
1.3.6 微观结构观察
将样品适当稀释后取10 μL置于洁净干燥的载玻片中央,并缓慢放下盖玻片,避免气泡的出现,固定于载物台,在400倍下观察目标样品的微观形态并拍摄记录。
1.3.7 乳液抑菌性能考察
1.3.7.1 抑菌圈直径(diameter of inhibition zone, DIZ)的测定
选用革兰氏阴性菌(大肠杆菌)和革兰氏阳性菌(金黄色葡萄球菌)作为研究对象。取各菌菌悬液(1×108 CFU/mL)100 μL涂布于营养琼脂培养基上,待菌液吸收后在琼脂平板上打孔并滴加一定体积过滤除菌的混合油相、不添加百里香酚的乳液(thyme essential oil- soybean oil nanoemulsion, TS-NE)和MONE(控制MONE中油含量与TS-NE、混合油相中油含量一致),无菌水为对照。将平板倒置于37 ℃培养24 h,用十字交叉法测量DIZ。
1.3.7.2 最小抑菌浓度(minimal inhibit concentration, MIC)和最小杀菌浓度(minimal bactericidal concentration, MBC)的测定
参考蒋书歌[15]的方法并稍作修改。采用二倍稀释法测定MONE的MIC和MBC。将MONE用LB肉汤培养基稀释成系列浓度并滴加至96孔板中,然后将100 μL菌液(1×106 CFU/mL)加入每个孔中。未添加菌液的孔作为空白对照组。将96孔板置于37 ℃下培养24 h,随后使用酶标仪在600 nm波长下测定各孔的吸光度。与空白对照吸光度相差小于0.05的乳液最低浓度定义为MIC值。再取100 μL各孔液体涂布于LB琼脂培养基,在37 ℃下培养24 h,以无微生物生长的平板最低浓度确定为乳液的MBC[16]。
1.4 数据分析
所有试验重复3次,数据用“平均数±标准偏差”表示,用Origin 2018作图,用SPSS 25.0进行差异显著性分析,以P<0.05为显著性差异。
2 结果与分析
2.1 水相pH对MONE粒径及包埋率的影响
如图1所示,在pH值为5.0时,接近WPI的等电点(pH 4.7),MONE的粒径较小,同时对混合油相拥有较高的包埋率。当pH值从5.0降低到4.0 时,WPI带电量增加,使得加热后蛋白质的聚集较为松散,从而导致WPI-LMP复合颗粒的粒径增大,当较大的复合颗粒乳化油相时形成的乳液液滴较大。有报道采用不同尺寸的单分散乳胶粒子(0.21~2.7 μm)制备皮克林乳液,发现随着乳胶粒子尺寸的增加,所得乳液液滴的粒径增加,乳液的稳定性下降[17]。当体系中水相pH值进一步升高,WPI与LMP同时带负电,二者之间的静电斥力增大,同时WPI-LMP复合颗粒的润湿性被影响[18],从而使其在油水界面上的吸附能力减弱、降低界面张力的能力下降,导致油滴无法得到有效乳化而聚集,液滴更易合并,从而使MONE的粒径增大,包封率也随之降低。这与闫紫玮等[19]的研究结果类似。因此选择在pH 5.0条件下制备MONE最佳。

图1 水相pH值对MONE粒径和包埋率的影响
Fig.1 Effect of aqueous pH values on particle size and encapsulation efficiency of MONE
注:同一指标,不同小写字母表示差异显著(P<0.05)(下同)。
2.2 WPI与LMP质量比对MONE粒径及包埋率的影响
如图2所示,随着LMP质量的增加,乳液粒径表现出增大的趋势,包埋率表现出先增大后减小的趋势。当乳液体系中LMP含量较少时,与WPI相互作用的LMP含量较少,导致WPI-LMP复合颗粒的疏水性较强,在乳化过程中较多颗粒分散在连续相而非油水界面[20],因此易发生油滴聚集,导致对油的包埋率偏低。当乳液体系中LMP质量大于WPI质量时,LMP 分子之间会发生桥接效应,彼此缠绕结合在WPI的外部,WPI-LMP整体形成一个核壳型结构的复合颗粒[9]。随着LMP含量的增加,包裹在WPI外部的多糖层逐渐变厚,使得WPI-LMP复合颗粒具备更强的空间位阻效应和乳化能力,从而减少MONE液滴间的吸引力,防止它们聚集和合并,进而降低乳液的粒径并能够包埋更多的油。但LMP含量过多时,与之发生静电相互作用的WPI饱和,多余的果胶分子引起纳米颗粒的聚集并降低纳米颗粒的稳定性,使液滴絮凝,导致乳液粒径增大、包埋率降低。刘炯娜等[21]以核桃蛋白和低聚半乳糖为原料制备的Pickering乳液中发现了类似的结果。综合粒径及包埋率变化,WPI与LMP质量比选择1∶2为最佳。

图2 WPI与LMP质量比对MONE粒径和包埋率的影响
Fig.2 Effect of WPI and LMP mass ratio on particle size and encapsulation efficiency of MONE
2.3 复合颗粒质量浓度对MONE粒径及包埋率的影响
如图3所示,随着复合颗粒质量浓度的增大,乳液的粒径呈先降低后增加的趋势,包埋率逐渐增加。其主要是由于复合颗粒质量浓度较低时,无法在油水界面形成一层连续稳定的乳化层,乳液体系不稳定[22],此外,由于缺乏足够的乳化剂颗粒来覆盖油滴表面,油滴易于聚集,因而MONE粒径较大、对油的包埋率偏低。随着复合颗粒浓度的增加,更多的复合颗粒会有助于提升体系的乳化能力,使乳液粒径变小并有效地包裹油滴,同时更多的复合颗粒有利于形成致密的油滴界面乳化层,更有效的防止乳液聚结;但是在过高的颗粒浓度下,颗粒间的范德华力等吸引力可能会促使颗粒相互吸引并聚集,油滴表面的吸附层变厚致使形成较大的乳液液滴。故MONE中复合颗粒的质量浓度确定为25 g/L较适宜。

图3 复合颗粒质量浓度对MONE粒径和包埋率的影响
Fig.3 Effect of composite particle concentration on particle size and encapsulation efficiency of MONE
2.4 油相体积对MONE粒径和包埋率的影响
由图4可知,随着油相体积的增加,MONE粒径及对油相的包埋率整体呈上升趋势,在油相体积为25 mL时,乳液拥有较小的粒径及较高的包埋率。当油相体积较小时,油水界面可用的油分较少,导致形成的乳液液滴较小。随着油相体积的增加乳化后可形成较大的液滴,使MONE的粒径增加,同时,可提供足够的界面供表面活性物质吸附,使WPI-LMP复合颗粒更好的发挥其乳化作用,从而提高乳液对油的包埋。而当油相的体积增加为30 mL时,乳液粒径继续增大,这可能是因为在颗粒浓度相同的情况下,有限的复合颗粒不足以乳化更多的油,油滴黏附于液滴表面,进而导致液滴发生黏连并聚集[23],因此乳液的液滴尺寸会增加。这一结果与黄欢等[24]的结果相似。综合以上选择在油相体积为25 mL条件下制备MONE。

图4 油相体积对MONE粒径和包埋率的影响
Fig.4 Effect of oil phase volume on particle size and encapsulation efficiency of MONE
2.5 百里香酚添加量对MONE粒径和包埋率的影响
百里香酚具有广谱抗菌活性,对大部分革兰氏阴性菌和阳性菌都有抑制作用[25]。百里香酚能破坏细菌细胞膜、减少微生物生物膜的形成、抑制微生物运动、抑制微生物ATP酶、抑制细菌外排泵,导致细胞死亡[26]。图5为百里香酚添加量对MONE粒径和包埋率的影响,为了显著提升混合油相纳米乳液的抗菌性,该试验选择百里香酚添加量为5%,此条件下MONE的粒径较小,包埋率可达到93%。

图5 百里香酚添加量对MONE粒径和包埋率的影响
Fig.5 Effect of thymol addition on particle size and encapsulation efficiency of MONE
2.6 MONE稳定性
2.6.1 pH稳定性及Na+稳定性
如图6所示,在pH 3~7的范围内MONE的粒径均较为稳定,不存在显著性差异,pH值的变化并未破坏乳液的稳定性。WPI-LMP通过多种相互作用形成的复合颗粒吸附在乳液液滴表面,表现出很好的水包油乳化性能[27],从而赋予了MONE在酸性范围的稳定性。MONE在较低Na+浓度时其粒径无显著变化,当Na+浓度增加到400 mmol/L时粒径显著增大,可能是盐离子的静电屏蔽作用使液滴间的斥力下降,乳液发生聚集所致[28]。MONE在pH 3~7及Na+浓度0~400 mmol/L时,其粒径波动分别在6.25%和12.5%左右,而类似研究表明,以百里香精油为油相制备的纳米乳在pH 2.5~6.5时其粒径波动在12.5%~25%[29],以芥末精油为油相制备的纳米乳的粒径在Na+浓度增加为400 mmol/L时,其粒径增长幅度约为120%[30],因此大豆油的加入使精油纳米乳液可以更好地抵抗pH及盐离子的影响。

a-不同pH值下MONE平均粒径;b-不同pH值下MONE外观;c-不同Na+浓度下MONE平均粒径;d-不同Na+浓度下MONE外观
图6 不同pH值和Na+浓度对MONE平均粒径及外观的影响
Fig.6 Effects of different pH values and Na+ concentrations on the average particle size and appearance of MONE
注:图b中从左至右MONE的pH值分别为3、4、5、6、7;图d中从左至右MONE的Na+浓度分别为50、100、200、400 mmol/L。
2.6.2 贮藏稳定性
从图7可以看出,乳液在4 ℃贮藏30 d未出现分层现象,说明MONE在长时间贮藏过程中仍然能够保持其原始特性。但随着贮藏时间的延长,在第15天乳液液滴粒径显著增加,通过光学显微镜微观形态图可以更加直观地看到乳滴之间发生聚集现象,这可能是由于Ostwald熟化作用,即小颗粒聚集形成较大颗粒[31]。但是到了25 d后,颗粒间聚集吸附能力达到饱和状态,小液滴和絮凝聚集物达到动态平衡,液滴的粒径都不再发生变化[32]。MONE在4 ℃下贮藏至第30天时,其粒径增加约为20%,袁雅雯[33]以栀子果油为油相制备的纳米乳液在4 ℃贮藏30 d时粒径增加30%,出现差异的原因可能是试验所用方法及乳化剂不同导致所制备的纳米乳液的性能不同。

a-粒径和包埋率;b-外观;c-光学显微镜
图7 4 ℃贮藏条件下30 d内MONE变化
Fig.7 Changes in MONE within 30 days under 4 ℃ storage conditions
2.7 MONE抑菌性能的测定
2.7.1 DIZ测定
如表1所示,MONE对大肠杆菌和金黄色葡萄球菌培养24 h的DIZ值分别为(26.50±0.50)和(25.00±0.25) mm,均大于20 mm,说明其对这2种细菌均具有高度敏感抑菌作用[34]。MONE对大肠杆菌比金黄色葡萄球菌的抑制能力更强,可能是因为百里香酚等抗菌成分具有较高的亲脂性,它们可能更容易穿透大肠杆菌的外膜,而金黄色葡萄球菌较厚的细胞壁可能阻碍了抗菌成分的渗透[35]。另一方面,纳米乳液对菌的DIZ值均大于混合油相的DIZ值,原因可能是混合油相的水溶性低,无法轻易与细胞膜相互作用,而乳液实现了对油的包封,纳米颗粒能够将油相带到细胞膜表面,从而可快速的侵入其细胞膜,导致细菌细胞膜的完整性被破坏,细胞质内容物泄漏,最终导致细胞死亡,导致内容物外泄,抑菌活性提高[16, 36-37]。此外,与TS-NE相比,MONE对2种菌的抑菌圈直径更大,这说明可能是因为百里香酚的加入使乳液中有效抗菌成分增多从而提高了MONE的抗菌能力,因此MONE对革兰氏阳性菌和革兰氏阴性菌均具有良好的抑菌活性。
表1 MONE对大肠杆菌及金黄色葡萄球菌抑菌圈直径的测定
Table 1 Determination of DIZ by MONE for Escherichia coli and Staphylococcus aureus

样品大肠杆菌/mm金黄色葡萄球菌/mm12 h24 h12 h24 h无菌水0a0a0a0a混合油相21.75±0.25b22.75±0.25b18.75±0.25b19.50±0.50bTS-NE24.25±0.25c24.50±0.50c22.75±0.25c23.00±0.25cMONE26.25±0.25d26.50±0.50d24.75±0.25d25.00±0.25d
注:同列不同小写字母表示同一菌种同一时间不同样品间差异显著(P<0.05)。
2.7.2 MIC和MBC的测定
使用二倍梯度稀释法测定了MONE的MIC和MBC,如表2和图7、图8所示。
表2 MONE对大肠杆菌和金黄色葡萄球菌的MIC的测定
Table 2 Determination of the MIC values of MONE against E. coli and S. aureus

试验菌MONE体积分数/(μL/mL)3.907.8115.6231.25大肠杆菌++--金黄色葡萄球菌++--
注:“+”表示有微生物生长,“-”表示没有微生物生长。
a-大肠杆菌;b-金黄色葡萄球菌
图8 MONE对不同菌种MBC值的测定
Fig.8 Determination of the MBC values of MONE against different bacterial species
金黄色葡萄球菌和大肠杆菌分别是典型的革兰氏阳性菌和革兰氏阴性菌,百里香精油对二者均具备抑制作用[38]。本试验中,令MONE在大肠杆菌及金黄色葡萄球菌菌悬液中体积分数为15.62 μL/mL(百里香精油体积分数为2.34 μL/mL)可抑制细菌的生长,MONE对大肠杆菌和金黄色葡萄球菌的MBC值均为31.25 μL/mL(百里香精油体积分数为4.68 μL/mL)。
3 结论
综上所述,负载百里香精油/大豆油/百里香酚混合油相的纳米乳液最佳制备工艺参数为:水相pH值为5、WPI与LMP质量比为1∶2、复合颗粒质量浓度为25 g/L、混合油相体积为25 mL、百里香酚添加量为混合油相体积的5%,该条件下MONE的平均粒径为(513±2.6) nm,包埋率为(93±0.36)%,在4 ℃贮藏30 d内MONE外观无明显变化,内部油滴尺寸缓慢增大,乳液总体稳定性较好,大豆油的添加减少了乳液粒径的变化。此外,MONE具有良好的pH稳定性和钠离子稳定性。抑菌实验表明,MONE对大肠杆菌和金黄色葡萄球菌均具有良好的抑菌活性,与不添加百里香酚的乳液相比,百里香酚的添加进一步提升了乳液的抗菌能力。然而,MONE在食品保鲜中的抑菌效果及对食品营养、感官及货架期等的影响需做进一步的系统评价。
[1] 刘婷. 基于百里香精油抗菌特性的自组装纳米乳对冷鲜猪肉保鲜作用的研究[D].西安:陕西师范大学, 2021.LIU T.Investigation of the preservative effects of self-assembled nanoemulsions derived from thymol-rich essential oil on the cold storage of fresh pork[D].Xi’an: Shaanxi Normal University, 2021.
[2] OZOGUL Y, KULEY BO A E, AKYOL I, et al.Antimicrobial activity of thyme essential oil nanoemulsions on spoilage bacteria of fish and food-borne pathogens[J].Food Bioscience, 2020, 36:100635.
A E, AKYOL I, et al.Antimicrobial activity of thyme essential oil nanoemulsions on spoilage bacteria of fish and food-borne pathogens[J].Food Bioscience, 2020, 36:100635.
[3] 徐冰, 徐少青, 刘锐, 等.百里香精油纳米乳液的制备及添加植物油对其理化性质及抑菌效果的影响[J].食品安全质量检测学报, 2022, 13(18):5861-5869.XU B, XU S Q, LIU R, et al.Preparation of Thymus vulgaris essential oil nanoemulsions and the effects of adding vegetable oils on its physicochemical and antibacterial properties[J].Journal of Food Safety &Quality, 2022, 13(18):5861-5869.
[4] EL-SAYED H S, CHIZZOLA R, RAMADAN A A, et al.Chemical composition and antimicrobial activity of garlic essential oils evaluated in organic solvent, emulsifying, and self-microemulsifying water based delivery systems[J].Food Chemistry, 2017, 221:196-204.
[5] ZHAO Y J, LIU R, QI C P, et al.Mixing oil-based microencapsulation of garlic essential oil:Impact of incorporating three commercial vegetable oils on the stability of emulsions[J].Foods, 2021, 10(7):1637.
[6] JULIAN MCCLEMENTS D, HENSON L, POPPLEWELL L M, et al.Inhibition of Ostwald ripening in model beverage emulsions by addition of poorly water soluble triglyceride oils[J].Journal of Food Science, 2012, 77(1):C33-C38.
[7] MENG Q, JIANG H Y, TU J X, et al.Effect of pH, protein/polysaccharide ratio and preparation method on the stability of lactoferrin-polysaccharide complexes[J].Food Chemistry, 2024, 456:140056.
[8] 李莫婷. 基于蛋白质与多糖相互作用的乳液界面组装及其对姜黄素与白藜芦醇的稳态机制[D].杨凌:西北农林科技大学, 2022.LI M T.Interfacial assembly of emulsions based on protein-polysaccharide interactions and its stabilization effect on curcumin and resveratrol[D].Yangling:Northwest A&F University.
[9] 刘珍珍, 辛颖, 张家豪, 等.乳清分离蛋白-苹果果胶协同稳定百里香精油Pickering乳液的制备及其抑菌保鲜性能研究[J].食品研究与开发, 2022, 43(19):1-9.LIU Z Z, XIN Y, ZHANG J H, et al.Preparation and antibacterial properties of thyme essential oil-loaded Pickering emulsion stabilized with whey protein isolate-apple pectin nanoparticle[J].Food Research and Development, 2022, 43(19):1-9.
[10] 秦云, 涂家生, 孙春萌.乳化剂乳化性能及其关键质量属性研究进展[J].药学研究, 2022, 41(4):236-241.QIN Y, TU J S, SUN C M.Research progress on emulsifying properties and critical quality attributes of emulsifiers[J].Journal of Pharmaceutical Research, 2022, 41(4):236-241.
[11] BAI L, HUAN S Q, LI Z G, et al.Comparison of emulsifying properties of food-grade polysaccharides in oil-in-water emulsions:Gum Arabic, beet pectin, and corn fiber gum[J].Food Hydrocolloids, 2017, 66:144-153.
[12] ONAIZI S A.Effect of oil/water ratio on rheological behavior, droplet size, zeta potential, long-term stability, and acid-induced demulsification of crude oil/water nanoemulsions[J].Journal of Petroleum Science and Engineering, 2022, 209:109857.
[13] GAO Y, LIN D H, PENG H N, et al.Low oil Pickering emulsion gels stabilized by bacterial cellulose nanofiber/soybean protein isolate:An excellent fat replacer for ice cream[J].International Journal of Biological Macromolecules, 2023, 247:125623.
[14] YANG H, SU Z W, MENG X H, et al.Fabrication and characterization of Pickering emulsion stabilized by soy protein isolate-chitosan nanoparticles[J].Carbohydrate Polymers, 2020, 247:116712.
[15] 蒋书歌. 柑橘精油纳米乳制备表征及其对金黄色葡萄球菌抗菌活性研究[D].长沙:湖南大学, 2021.JIANG S G.Study on preparation and characterization of citrus essential oil nanoemulsions and its antibacterial activity against Staphylococcus aureus[D].Changsha:Hunan University, 2021.
[16] MOGHIMI R, GHADERI L, RAFATI H, et al.Superior antibacterial activity of nanoemulsion of Thymus daenensis essential oil against E.coli[J].Food Chemistry, 2016, 194:410-415.
[17] BINKS B P, LUMSDON S O.Pickering emulsions stabilized by monodisperse latex particles:effects of particle size[J].Langmuir, 2001, 17(15):4540-4547.
[18] 孙翠霞, 刘夫国, 杨伟, 等.生物来源的固体颗粒制备Pickering 乳液的研究进展[J].食品工业科技, 2015, 36(15):370-375;381.SUN C X, LIU F G, YANG W, et al.Research progress in Pickering emulsions stabilized with biomass-based solid nanoparticles[J].Science and Technology of Food Industry.2015, 36(15):370-375;381.
[19] 闫紫玮, 郭瑞阳, 王小雪, 等.玉米醇溶蛋白/果胶稳定的肉桂精油皮克林乳液制备工艺的优化[J].中国食品学报, 2023, 23(3):260-270.YAN Z W, GUO R Y, WANG X X, et al.Optimization of preparation process for cinnamon essential oil-encapsulated Pickering emulsion stabilized by zein/pectin composite colloidal particles[J].Journal of Chinese Institute of Food Science and Technology, 2023, 23(3):260-270.
[20] 吴滋灵. 玉米醇溶蛋白胶体颗粒稳定的高内相Pickering乳液制备及其营养输送特性研究[D].广州:华南理工大学, 2018.WU Z L. Fabrication of high internal Pickering emulsions stabilized by zein colloid particles and the research of its nutrient transport characteristics[D].Guangzhou:South China University of Technology, 2018.
[21] 刘炯娜, 张丹, 蒋雨心, 等.核桃蛋白-低聚半乳糖复合纳米颗粒的制备及其Pickering乳液性质[J].精细化工, 2024, 41(7):1 590-1598;1614.LIU J N, ZHANG D, JIANG Y X, et al.Preparation of walnut protein isolate-galactooligosaccharides composite nanoparticles and properties of their Pickering emulsion[J].Fine Chemicals, 2024, 41(7):1 590-1598;1614.
[22] CAI Z X, WEI Y, SHI A M, et al.Correlation between interfacial layer properties and physical stability of food emulsions:Current trends, challenges, strategies, and further perspectives[J].Advances in Colloid and Interface Science, 2023, 313:102863.
[23] ZHOU Y, SUN S S, BEI W Y, et al.Preparation and antimicrobial activity of oregano essential oil Pickering emulsion stabilized by cellulose nanocrystals[J].International Journal of Biological Macromolecules, 2018, 112:7-13.
[24] 黄欢, 田燕, 刘一哲, 等.椰子油纳米乳液制备工艺优化及其稳定性分析[J].食品工业科技, 2023, 44(9):10-19.HUANG H, TIAN Y, LIU Y Z, et al.Optimization of preparation technology and stability analysis of coconut oil nanoemulsion[J].Science and Technology of Food Industry, 2023, 44(9):10-19.
[25] 窦秀静, 房春洋, 皇甫迎旭, 等.百里香酚的功能及其在动物生产中的应用[J].动物营养学报, 2020, 32(12):5491-5499.DOU X J, FANG C Y, HUANGFU Y X, et al.Function of thymol and its application in animal production[J].Chinese Journal of Animal Nutrition, 2020, 32(12):5491-5499.
[26] RATHOD N B, KULAWIK P, OZOGUL F, et al.Biological activity of plant-based carvacrol and thymol and their impact on human health and food quality[J].Trends in Food Science &Technology, 2021, 116:733-748.
[27] TANG C H.Globular proteins as soft particles for stabilizing emulsions:Concepts and strategies[J].Food Hydrocolloids, 2020, 103:105664.
[28] NOOSHKAM M, VARIDI M.Physicochemical stability and gastrointestinal fate of β-carotene-loaded oil-in-water emulsions stabilized by whey protein isolate-low acyl gellan gum conjugates[J].Food Chemistry, 2021, 347:129079.
[29] 刘珍珍. 果胶酯酶响应型纳米复合涂膜体系的构建及其保鲜效果的研究[D].郑州:河南工业大学, 2023.LIU Z Z.Construction and preservation effect of pectin methyl esterase responsive nanocomposite coating system[D].Zhengzhou:Henan University of Technology, 2023.
[30] 袁楚珊, 程小梅, 孙畅, 等.添加柑橘果胶和吐温-80的芥末精油纳米乳液稳定性、抑菌活性及其在砂糖橘保鲜中的应用[J].食品科学, 2024, 45(16):213-222.YUAN C S, CHENG X M, SUN C, et al.Stability and bacteriostatic activity of mustard essential oil nanoemulsion fortified with Citrus pectin and Tween-80 and its application in the preservation of ‘shatangju’ mandarin[J].Food Science, 2024, 45(16):213-222.
[31] 邵颖. 壳聚糖-丁香酚乳液的制备表征及其对冷藏期间带鱼的保鲜作用研究[D].杭州:浙江大学, 2019.SHAO Y.The preparation and characterization of eugenol loaded chitosan emulsions and their preservation effect on hairtail meat during cold storage[D].Hangzhou:Zhejiang University, 2019.
[32] 周增超. 燕麦蛋白—壳聚糖相互作用机制及复合乳液的应用研究[D].天津:天津科技大学, 2022.ZHOU Z C.Study on the interaction mechanism of oat protein and chitosan and application of compound emulsion[D].Tianjin:Tianjin University of Science and Technology, 2022.
[33] 袁雅雯. 栀子果油的超声辅助水酶法提取及其纳米乳液制备的研究[D].杭州:浙江科技学院, 2023.YUAN Y W.Study on ultrasound-assisted aqueous enzymatic extraction of gardenia fruit(Gardenia jasminoids Ellis)oil and preparation of nanoemulsions[D].Hangzhou:Zhejiang University of Science and Technology, 2023.
[34] ROTA M C, HERRERA A, MART NEZ R M, et al.Antimicrobial activity and chemical composition of Thymus vulgaris, Thymus zygis and Thymus hyemalis essential oils[J].Food Control, 2008, 19(7):681-687.
NEZ R M, et al.Antimicrobial activity and chemical composition of Thymus vulgaris, Thymus zygis and Thymus hyemalis essential oils[J].Food Control, 2008, 19(7):681-687.
[35] 童金蓉, 张昭寰, 黄振华, 等.革兰氏阴性细菌外膜主要成分的跨膜转运机制研究进展[J].生物化学与生物物理进展, 2020, 47(6):510-522.TONG J R, ZHANG Z H, HUANG Z H, et al.Research progress on transmembrane transport mechanisms for the main components of the outer membrane in gram-negative bacteria[J].Progress in Biochemistry and Biophysics, 2020, 47(6):510-522.
[36] MARCHESE A, ORHAN I E, DAGLIA M, et al.Antibacterial and antifungal activities of thymol:A brief review of the literature[J].Food Chemistry, 2016, 210:402-414.
[37] 史沛青, 郑艳茹, 陈晖, 等.改性凹凸棒黏土/羧甲基壳聚糖协同稳定桉叶精油Pickering乳液制备及缓释抑菌性能[J].食品科学, 2022, 43(18):47-54.SHI P Q, ZHENG Y R, CHEN H, et al.Preparation and sustained-release antibacterial activity of eucalyptus leaf essential oil Pickering emulsion stabilized by modified attapulgite nanoparticles and carboxymethyl chitosan[J].Food Science, 2022, 43(18):47-54.
[38] HU L B, BAN F F, LI H B, et al.Thymol induces conidial apoptosis in Aspergillus flavus via stimulating K+ eruption[J].Journal of Agricultural and Food Chemistry, 2018, 66(32):8530-8536.